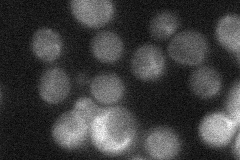
YCR083W

View description
Mitochondrial thioredoxin, highly conserved oxidoreductase required to maintain the redox homeostasis of the cell, forms the mitochondrial thioredoxin system with Trr2p, redox state is maintained by both Trr2p and Glr1p
Localization:
Intensity:
Fold change:
Significance:
-
C’ GFP library in SD

mitochondria32.81 -
N' NOP1pr-GFP in SD

mitochondria167.347 -
N' TEF2pr-mCherry in SD

mitochondria272.942 -
N' NATIVEpr-GFP in SD
cytosol,punctate33.0803 -
N' TEF2pr-VC and Cyto-VN in SD

#N/A0 -
C’ GFP library in SD+DTT

mitochondria29.180.88No -
C’ GFP library in SD+H2O2

mitochondria27.440.83No -
C’ GFP library in Starvation Media

mitochondria95.22.9Yes -
C’ GFP library on the background of Pup2-DaMP

mitochondria -
C’ GFP library on the background of CCT mutant

mitochondria27.44940.836474No
